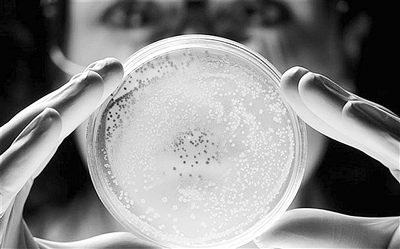

今日视点
据英国《每日电讯报》7月31日报道,美国斯坦福大学的科学家和素有“科学怪才”之称的克雷格·文特尔领导的科研小组在《细胞》杂志上撰文指出,他们首次利用计算机制造出了“虚拟细菌”,其能模拟微生物的生命轨迹和一举一动。科学家们表示,最新突破或许有助于改进人类对疾病的理解并为疾病找到新的疗法。
《每日电讯报》在报道中指出,生物学和计算机科学的联姻让科学家们能借用计算机脚本模拟生命,这将让人类大大受益,并有助于回答人类最大也最基本的问题“生命是什么?”。
“代码脚本”首次让生物和计算机“联姻”
自古以来,当两种不同的科学思维碰撞在一起时,都会激起人们灵感的火花,让人类做出更重大的科学突破,分子生物学的诞生就是如此。上世纪50年代中叶,研究遗传学的生物学家开始同使用X射线研究物质原子结构的物理学家们合作,这场“联姻”让人类首次看到了DNA优雅的双螺旋结构,分子生物学(在分子水平上研究生命现象的科学,主要通过研究核酸、蛋白质等生物大分子的结构、功能和生物合成等方面来阐明各种生命现象的本质,研究内容包括光合作用、癌症的发生等各种生命过程)这门新兴学科也在1953年顺势兴起,将对人类自身和疾病的研究推到更高的层次。
无独有偶,另外两门科学也在慢慢靠近并相互结合。其中一个科学领域是生物学,主要专注于研究DNA指令,正是这些指令决定了活体生物是如何建立起来以及如何运转的;另一个领域计算机科学则专注于研究操作计算机运行的代码。
备受争议的基因组研究先锋、美国生物学家克雷格·文特尔目前是让这两门科学“联姻”的积极推手,其实,奥地利的量子力学天才埃尔温·薛定谔早在1943年提出的“代码脚本”这一概念正是生物学和计算机科学结合的雏形。
薛定谔于1943年发表了一场具有里程碑意义的演讲,在那场演讲中,薛定谔提出了一个天才性的问题:生命是什么?薛定谔问道:一个受精卵如何能获得“一些包含了该生物未来所有发育信息的代码脚本。”为了回答这个问题,薛定谔提出,染色体就像“非周期性(大分子)晶体”一样,是一种由同分异构元素连续组成的非周期晶体,构成其的原子具有一个复杂的非重复性的模式;他也描述了该大分子内“原子排列有序的结合”像摩斯代码中的划线和点一样,拥有建立微生物的指令。
这是科学家们首次对遗传代码进行严肃的讨论,尽管与很多同龄人一样,薛定谔也曾错误地认为,遗传代码被写入蛋白质而非核酸中。然而,基于他1943年的演讲而撰写的《生命是什么》这本书却给了很多人灵感。其中包括DNA研究领域的开创者、DNA双螺旋结构的发现者之一吉姆·沃森和文特尔。文特尔在演讲中表示:“薛定谔的‘代码脚本’为未来的很多发现指明了方向。”
用计算机脚本模拟细菌
现在,文特尔正在撰写他自己的代码脚本——使用计算机设计基因组。他说:“我们正在尝试利用计算机,使用遗传代码合成出基因组,让计算机科学和生物学完美地联姻。”
实际上,计算机不仅能模拟生命,也能模拟活着的细胞。几天前,为了帮助人类理解一个细胞的复杂性,斯坦福大学的马库斯·卡沃特领导的科研团队与文特尔的研究机构携手合作,制造出了虚拟的生殖支原体细菌,并再现了该细菌的整个生命循环过程。该细菌是所有细菌中最简单的一种,它拥有已知的活体生物中最小的基因组,并且是第二种被排序的非共生微生物。1995年,文特尔对其基因组进行了排序。
生殖支原体细菌目前已经成为首个被详细建模的微生物,科学家们使用128台计算机,模拟出了其525个基因中每一个基因的详细情况,也在分子层面绘制出了该细菌从DNA到RNA再到名为代谢物的小分子的情况。
科学家们表示,虚拟细胞和虚拟细菌将帮助他们厘清生命和疾病的本质。当人们谈论某个“癌症基因”时,其意思是,他们发现了一个基因,当该基因出故障时,会引发癌症。但是,当人们详细研究一个癌细胞时就会发现,体内2.3万个基因中的大部分基因都会受到影响,模拟基因组的整个工作情况,对于理解造成疾病的遗传原因至关重要。
文特尔表示,用计算机来模拟生命、设计生命并“再现生命”,标志着科学研究将跨入一个新领域,借此,人类会比以往更接近“生命是什么”这一终极问题的答案。(记者 刘霞 综合外电)
编辑:朱芙蓉
新闻来源:http://www.stdaily.com/stdaily/content/2012-08/03/content_502580.htm

留言